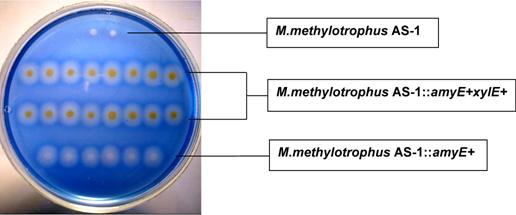

На правах рукописи
ТОКМАКОВА ИРИНА ЛЬВОВНА
РАЗРАБОТКА МЕТОДОВ НАПРАВЛЕННОЙ МОДИФИКАЦИИ БАКТЕРИАЛЬНОЙ ХРОМОСОМЫ ДЛЯ МЕТАБОЛИЧЕСКОЙ ИЖЕНЕРИИ ОБЛИГАТНОГО МЕТИЛОТРОФА
METHYLOPHILUS METHYLOTROPHUS AS1
03.01.03. – Молекулярная биология
АВТОРЕФЕРАТ
диссертации на соискание ученой степени
кандидата биологических наук
Москва 2010
Работа выполнена в лаборатории №3 Научно-исследовательского института «Аджиномото-Генетика» ()
Научные руководители:
кандидат биологических наук
кандидат биологических наук Ю.
Официальные оппоненты:
доктор биологических наук, проф.
»
кандидат биологических наук
Институт молекулярной генетики РАН
Ведущая организация:
Институт общей генетики им. РАН
Защита диссертации состоится « 25 » мая 2010 года в 1400 на заседании Диссертационного 217.013.01 при » г. Москва, 1-й Дорожный проезд, д. 1
С диссертацией можно ознакомиться в библиотеке »
Автореферат диссертации разослан « 22 » апреля 2010 года.
Ученый секретарь Диссертационного Совета,
кандидат химических наук
ОБЩАЯ ХАРАКТЕРИСТИКА РАБОТЫ
Актуальность проблемы. Забота об окружающей среде в условиях быстрого индустриального развития многих стран мира делает необходимым переход промышленных процессов на качественно новый технологический уровень, направленный на использование возобновляемых природных ресурсов и минимизацию потерь. Одним из направлений решения данной задачи является сочетание «мягких» в отношении окружающей среды микробиологических процессов с дешевыми и легкодоступными видами сырья. К таким видам сырья можно отнести метанол, получаемый из природного газа и имеющий сравнительно низкую стоимость. В последнее время в биотехнологической индустрии метанолу уделяется большое значение, как альтернативному источнику углерода широко используемым для этих целей сахарам.
Бактерии, способные расти на метаноле, широко распространены в природе и характеризуются большим разнообразием. Доступность сырья и его сравнительно невысокая стоимость позволяют рассматривать метилотрофы в качестве перспективных и выгодных объектов индустриальной биотехнологии. В настоящее время метилотрофные бактерии все шире используются в промышленности для производства таких важных биологически активных веществ, как: секретируемые природные и рекомбинантные белки (Belanger L. et al., 2004; Fitzgerald K. and Lidstrom M., 2003) витамины, ферменты, полисахариды, аминокислоты (Bourque D. et al., 1995; Korotkova N. et al., 2002; Motoyama H. et al., 1993, 2001; Tani Y., 1991).
Создание штаммов-продуцентов с заданными свойствами и высокой эффективностью продукции предполагает детальное знание генетики организма, его метаболитических путей, процессов регуляции клеточного метаболизма, а также наличия определенного набора генетических методов, необходимых для направленной модификации исследуемого объекта. Промышленное использование метилотрофов значительно увеличило интерес к изучению генетического контроля С-1 метаболизма у определенных видов этих бактерий (Anthony C., 1993). За последние 5 лет были секвенированы геномы некоторых метилотрофных микроорганизмов (Chistoserdova L. et al., 2007; Giovannoni S. et al., 2008; Hou S. et al., 2008; Kane S. et al., 2007; Vuilleumier S. et al., 2009; Ward N. et al., 2004), значительный прогресс достигнут в понимании их метаболизма (Growther G. et al., 2008) и существенно расширен набор полезных методов для генетической и метаболической инженерии (Сue D. et al., 1997; Gliesche C., 1997; Marx C. and Lidstrom M., 2001). К таким методам можно отнести, например, недавнее использование системы транспозона Tn7 для сайт-специфической интеграции в геном метилотрофов рекомбинантных ДНК (Choi Y. et al., 2006). Однако и сейчас большинство метилотрофов плохо изучены и набор генетических инструментов для работы с ними сильно ограничен. По этой причине разработка новых подходов генетического анализа метилотрофрых бактерий с их последующим применением в конструировании штаммов-продуцентов представляется на данном этапе актуальной.
Methylophilus methylotrophus AS1, являющийся объектом наших исследований, в 70-е годы прошлого века был широко использован в микробиологической индустрии для производства бактериальной биомассы (Senior P.. and Windass J., 1980, Vasey R. and Powell K., 1984). В связи с чем начальные стадии углеродного и энергетического метаболизма этого организма в этот период были всесторонне исследованы (Cox J. et al., 1992; Hothi P. et al., 2003), однако мало что известно о метаболитических путях биосинтеза аминокислот в M. methylotrophus. Недавно специалистами Аджиномото (Ajinomoto Co, Inc.) было проведено изучение синтеза L-лизина у M. methylotrophus, начиная с исследования путей биосинтеза (Gunji Y. et al., 2004; Tsujimoto N. et al., 2006) и заканчивая конструированием и усовершенствованием продуцента L-лизина на метаноле (Gunji Y. et al., 2006; Gunji Y. and Yasueda H., 2006; Ishikawa K. et al., 2Задачей наших исследований было создание методов, облегчающих создание на основе M. methylotrophus штаммов-продуцентов ароматических аминокислот. Как известно, на первом этапе конструирования продуцентов аминокислот необходимо отобрать мутанты с ослабленным ингибированием ключевых ферментов конечным продуктом биосинтеза и блокировать возможные пути деградации целевого продукта и его предшественников созданием соответствующих ауксотрофных мутантов (Bongaerts J. et al., 2001; Ikeda M., 2006; Parekh S. et al., 2000). Для облигатных метилотрофов получение ауксотрофных мутантов является особой трудностью (de Vries G. et al., 1990). Причиной может быть неспособность некоторых соединений проникать внутрь и экспортироваться из клеток этих микроорганизмов. И хотя отдельные случаи получения ауксотрофных мутантов у M. methylotrophus AS1 все же были описаны (Bohanon M. et al., 1988; Gunji Y. et al., 2004; Kim C. and Wood T., 1997), их число сильно ограничено. Кроме того, применение различных подходов и разработка новых методов для получения мутантов не привели к созданию коллекции ауксотрофных мутантов M. methylotrophus AS1, которые могли быть полезными для исследования путей биосинтеза аминокислот. С другой стороны, имевшиеся в литературе (Tsujimoto N. et al., 2006; Gunji Y. and Yasueda H., 2006), а также и наши собственные экспериментальные данные свидетельствовали в пользу того, что многие клонированные гены E. coli способны достаточно эффективно экспрессироваться в M. methylotrophus, что позволяло надеяться на возможное практическое использование уже хорошо разработанных генетических модулей и систем для функционирования в этих новых реципиентах.
В последнее время в молекулярной биологии большое внимание уделяется изучению транспортных систем клетки. Мы надеялись, что использование гетерологичных генов E. coli, кодирующих специфические транспортные белки, поможет увеличить проницаемость цитоплазматической мембраны M. methylotrophus, и, возможно, облегчит процедуру получения ауксотрофных мутантов.
В настоящее время развитие генетических инструментов для изучения метилотрофов включает в себя создание плазмидных векторов для клонирования и экспрессии генов, а также совершенствование методов транспозонного мутагенеза (Marx C., and Lidstrom M., 2004; Koch B. et al., 2001). Поскольку из-за существующих законодательных ограничений использование плазмид нежелательно при создании промышленных продуцентов биологически активных веществ, то приоритетное значение имеет дальнейшее развитие методов конструирования бесплазмидных рекомбинантных штаммов. Нам представлялось, что и система транспозиции хорошо известного фага Mu (Symonds N. et al., 1987) также могла быть успешно адаптирована для интеграции фрагментов ДНК в геном M. methylotrophus.
Цель и задачи работы. Таким образом, целью настоящей диссертационной работы была разработка новых генно-инженерных подходов для направленной модификации бактериального генома M. methylotrophus при создании бесплазмидных рекомбинантных штаммов-продуцентов.
В соответствии с этим были поставлены следующие задачи:
1. исследовать возможность адаптации системы транспозиции бактериофага Mu для интеграции рекомбинантной ДНК в хромосому M. methylotrophus AS1, в том числе:
· сконструировать интегративные плазмиды, содержащие mini-Mu транспозон с FLP-FRT-вырезаемым селективным маркером устойчивости к канамицину и способные к мобилизационному переносу из клеток E. coli в клетки M. methylotrophus AS1;
· осуществить конструирование хелперных плазмид, содержащих термоиндуцибельные гены факторов транспозиции MuA, MuB и способных к репликации в клетках M. methylotrophus AS1;
· исследовать возможность интеграции и амплификации mini-Mu транспозона в хромосоме M. methylotrophus AS1;
· изучить влияние энхансерной последовательности (IAS) бактериофага Mu на амплификацию mini-Mu в хромосоме M. methylotrophus AS1;
2. создать коллекцию ауксотрофных мутантов c нарушенным биосинтезом ароматических аминокислот у M. methylotrophus AS1, для чего:
· сконструировать специальный штамм M. methylotrophus AS1::aroPEco с повышенной проницаемостью цитоплазматической мембраны к ароматическим веществам;
· клонировать гены ароматического пути биосинтеза M. methylotrophus AS1;
· инактивать гены ароматического пути биосинтеза в хромосоме M. methylotrophus AS1::aroPEco.
Научная новизна и практическая ценность работы. Двухплазмидная система транспозиции бактериофага Mu успешно адаптирована для целей интеграции рекомбинантной ДНК в хромосому M. methylotrophus AS1.
Установлено, что основным механизмом функционирования mini-Mu-транспозона в клетках метилотрофов в рамках данной системы является репликативная транспозиция, за счет которой может быть осуществлена амплификация интегрированных фрагментов ДНК в бактериальном геноме.
Показано, что наличие энхансерной последовательности фага в составе mini-Mu транспозона существенно увеличивает эффективность транспозиции в хромосоме M. methylotrophus AS1. Данная система представляет собой удобный генетический инструмент, прикладным значением которого является конструирование бесплазмидных безмаркерных штаммов-продуцентов биологически активных веществ.
Сконструирован штамм Methylophilus methylotrophus AS1::aroPEco с геном транспортера aroPEco, интегрированным в хромосому, и обладающий повышенной проницаемостью цитоплазматической мембраны к ароматическим веществам. На основе этого штамма создана коллекция ауксотрофных мутантов с нарушенным биосинтезом ароматических аминокислот.
Разработанные генетические инструменты были успешно использованы в работах НИИ «Аджиномото-Генетика» при конструировании метанол утилизирующих штаммов-продуцентов L-фенилаланина.
Публикации и апробация работы. По теме диссертации опубликовано 7 печатных работ, из них 6 в журналах, рекомендованных ВАК, и 1 патентная заявка. Материалы диссертации докладывались на конкурсе работ сотрудников (июнь 2004) и Международной научной конференции (Лиссабон, декабрь 2010 г). Диссертационная работа была апробирована на совместном семинаре НТС и секции «Молекулярная биология» Ученого Совета марта 2010 года.
Стуктура и объем работы. Диссертация состоит из 6 разделов: «Введение», «Обзор литературы», «Материалы и методы», «Результаты и обсуждение», «Выводы» и «Список цитируемой литературы». Работа изложена на страницах, включая 23 рисунка и 7 таблиц. Список цитируемой литературы содержит источника, в том числе 5 на русском языке.
ОСНОВНОЕ СОДЕРЖАНИЕ РАБОТЫ
1. Адаптация системы транспозиции бактериофага Mu для интеграции рекомбинантной ДНК в хромосому M. methylotrophus AS1.
Бактериофаг Mu на разных стадиях жизненного цикла использует два альтернативных механизма транспозиции: прямую интеграцию и репликативную транспозицию через образование коинтегратов. Оба эти механизма инициируется процессом формирования транспозосомы, а затем рекомбинационного комплекса, в которых помимо Mu-специфических белков (MuA и MuB) и участков ДНК фага (Mu-attL, Mu-attR) принимает участие большое число белков клетки-хозяина, как минимум, на этапе формирования транспозосомы, гистоноподобные белки HU и IHF. Что касается последних, то представители семейства таких ДНК-изгибающих белков достаточно часто встречаются в клетках различных прокариот (Swinger K. and Rice P., 2004). Поэтому можно было ожидать, что система транспозиции фага Mu будет также функционировать и в других бактериях.
Разработанная в АГРИ ранее ( и др., 2007) Mu-зависимая система для интеграции рекомбинантных ДНК в геном E. coli включает две совместимые плазмиды, имеющие относительно нестабильные репликоны. Первая из них, хелперная, содержит гены Mu-A и Mu-B, экспрессия которых репрессирована вследствие присутствия на плазмиде гена термочувствительного репрессора – cts62 и может быть индуцирована повышением до 42оС температуры культивирования клеток. Вторая плазмида, интегративная, содержит mini-Mu-транспозон, фланкированный линейными фрагментами ДНК фага – Mu-attL и Mu-attR, с участками для встраивания селективного маркера и целевых генов.
Данную систему используют, как правило, следующим образом. В клетки, уже содержащие хелперную плазмиду, вводят интегративную плазмиду, параллельно проводя термоиндукцию синтеза факторов транспозиции, и отбирают клоны с интегрированным в бактериальный геном mini-Mu-транспозоном. При необходимости потомки клеток-интегрантов «излечивают» от автономно реплицирующихся плазмид.
В описанной системе обе плазмиды, содержащие компонентны Mu-зависимой транспозиции, были не способны к репликации в широком круге организмов, в частности, в M. methylotrophus. Поэтому для проверки функциональности и активности системы транспозиции фага Mu в новом организме, предстояло модифицировать обе группы рекомбинантных ДНК.
1.1. Конструирование хелперных плазмид с термоиндуцибельными генами факторов Mu-зависимой транспозиции.
Модификация хелперной плазмиды заключалась в замене ColE-подобного репликона ранее сконструированной в АГРИ плазмиды pUC-MuAB ( и др., 2007) на репликоны векторов широкого круга хозяев – IncQ и IncP групп несовместимости (Рис. 1).

Рис. 1. Схема конструирования и физико-генетическая карта хелперных плазмид pTP310 и pAET7.
Первый из использованных для этих целей векторов, pAYC32, имел репликон плазмиды RSF1010 IncQ-группы (Guerry P. et al, 1974). Полученная плазмида pAET7 (ApR, SmR) стабильно наследовалась в клетках M. methylotrophus (доля клеток, потерявших плазмиду при росте при 30оС в течение 20 генераций в неселективных условиях, не превышала 2%), но при необходимости эта плазмида могла быть элиминирована с частотой не менее 30%. С этой целью бактерии выращивали в течение 24-48 часов в среде с акридином оранжевым (25-30 мкг/мл) или повышали температуру культивирования с 30 оС до 37оС.
Вторая из полученных плазмид – pTP310 (Рис. 1), была сконструирована на основе вектора pRK310, делеционного производного плазмиды RP4/RK2 IncPa-группы (Pansegrau W. et al, 1994). pTP310 имела маркер устойчивости к тетрациклину (TcR) и обладала способностью к RP4-зависимой мобилизации. Однако в клетках M. methylotrophus pTP310 можно было поддерживать только в строго селективных условиях – при аэробном культивировании в жидкой среде без антибиотика при 30оС плазмида утрачивалась из 70% клеток в течение 24 часов (и 100% клеток теряли плазмиду за 48 часов).
Таким образом, для исследования Mu-зависимой транспозиции в M. methylotrophus было осуществлено конструирование двух вариантов мобилизуемых хелперных плазмид на основе стабильного (плазмида pAET7), и нестабильного (плазмида pTP310) в клетках метилотрофов репликонов, что может значительно расширить экспериментальные возможности использования этой системы для генетических модификаций штаммов. В частности, хелперы со стабильными репликонами перспективны для проведения множественных последовательных интеграций различных mini-Mu-транспозонов в один и тот же штамм. В то же время использование нестабильных хелперов удобно для проведения одного цикла интеграции с получением в конечном итоге бесплазмидного варианта.
1.2. Конструирование mini-Mu-содержащих интегративных векторных плазмид, способных к мобилизационному переносу в M. methylotrophus.
Для создания мобилизуемого интегративного вектора была использована плазмида – pMIV5 ( и др., 2008). Эта плазмида с репликоном pSC101 была сконструирована в АГРИ ранее в результате интеграции mini-Mu MD4041 в pMW1 ( и др., 2007) с последующим удалением практически всей внутренней части исходного транспозона между Mu-attL и Mu-attR и встраиванием некоторых терминаторов транскрипции и последовательности полилинкера. Дальнейшая модификация этой плазмиды была связана с обеспечением возможности ее мобилизационного переноса в клетки M. methylotrophus.
Для этого в участок, несущественный для репликации pMIV5 и расположенный на плазмиде вне mini-Mu-транспозона, был клонирован фрагмент ДНК, содержащий oriT сайт RP4 (Simon R. et al, 1983). (Рис. 2 А).
А. Б.

Рис. 2. Физико-генетическая карта интегративных плазмид.
Чтобы обеспечить селективность процесса интеграции целевого фрагмента, и в то же время получить возможность конструирования в конечном итоге штаммов, не содержащих маркеров устойчивости к антибиотикам, в состав mini-Mu-транспозона был введен также маркер устойчивости к канамицину, фланкированный сайтами FLP-FRT-зависимой рекомбинации из pKD4 (Datsenko K. and Wanner B., 2000) (Рис. 2 Б).
1.3. Mu-зависимая транспозиция маркера устойчивости к канамицину
в хромосому M. methylotrophus.
Первые эксперименты по интеграции mini-Mu в хромосому M. methylotrophus AS1 проводили с использованием стабильной хелперной плазмиды pAET7. Хелперную и интегративную плазмиды последовательно вводили в клетки M. methylotrophus путем RP4-зависимой мобилизации. При этом интегративная плазмида не обладала способностью к репликации в данном организме. Проведение мобилизации в условиях термоиндукции синтеза факторов транспозиции MuA, MuB, с последующей селекцией на среде с канамицином позволило отобрать варианты, стабильно наследовавшие KmR-маркер mini-Mu-транспозона. Частота образования интегрантов была 10-2¸10-3 относительно числа исходных клеток донорного штамма, что соответствовало эффективности плазмидной мобилизации, то есть практически в каждой клетке реципиентного штамма, получившей интегративную плазмиду, произошла транспозиция KmR-маркера. После излечивания KmR-клеток от pAET7 наличие в бактериальной хромосоме mini-Mu было подтверждено генетическим анализом (ApS) и с помощью PCR.

Рис. 3. Схема прямой интеграции (А) и репликативной транспозиции (Б) mini-Mu-транспозона, содержащего KmR-маркер (обозначен стрелкой), из нереплицирующегося в клетках M. methylotrophus AS1 интегративного вектора (И) в бактериальную хромосому (Б) в присутствии хелперных плазмид (Х), имеющих в своем составе различные маркеры устойчивости к антибиотикам: ApR, SmR или TcR.
Использование в этих экспериментах стабильной хелперной плазмиды, pAET7, не позволяло установить по какому из известных механизмов – прямой интеграции или репликативной транспозиции с образованием коинтегратов – осуществляется встраивание mini-Mu в геном M. methylotrophus. Поскольку, и интегративная, и хелперная плазмиды имели АрR-маркер, то до излечивания от хелпера потенциально образующиеся ApR, KmR-коинтеграты генетически были неотличимы от KmR-продуктов «простой инсерции» mini-Mu. В ходе длительной процедуры элиминации стабильной pAET7 образовавшиеся на первых стадиях коинтеграты имели возможность разрешаться в результате гомологичной рекомбинации между двумя копиями mini-Mu транспозона (Рис. 3).
Для того чтобы попытаться зафиксировать существование коинтегратов, в качестве хелперной плазмиды использовали pTP310, имеющую селективный маркер TcR и не содержащую ApR. В результате лишь 30% клонов, отобранных в этом эксперименте имели фенотип KmR, ApS, то есть являлись следствием либо прямой интеграции, либо репликативной транспозиции, но с уже разрешенным коинтегратом. Тогда как 70% проверенных клонов имели фенотип KmR, ApR, а, значит, структура их хромосомы являлась коинтегратом, образовавшимся в результате репликативной транспозиции (Рис. 3 Б). Дальнейшее культивирование этих клонов на среде с канамицином, но без ампициллина достаточно быстро приводило к выщеплению KmR, ApS-вариантов – продуктов разрешения коинтеграта.
Таким образом, при использовании интегративных плазмид, не способных к автономной репликации в клетках метилотрофов, механизм репликативной транспозиции является, как минимум, значительно более вероятным, чем прямая интеграция mini-Mu-транспозона в бактериальную хромосому. Предположение о возможности адаптации системы транспозиции бактериофага Mu для клеток метилотрофов базировалось на известной функциональной гомологии ДНК-изгибающих белков различных бактерий. При этом реализация самой транспозиции по механизму прямой интеграции представлялась более вероятной, чем репликативная транспозициия, поскольку в первом случае осуществляется лишь репаративный, но не репликативный синтез ДНК при рекомбинации, а следовательно, в этом процессе принимает участие меньшее число специфичных белков клетки-хозяина. Тем не менее, именно репликативная транспозиция являлась в случае использованной системы основным путем интеграции mini-Mu в геном метилотрофов. Тем самым было экспериментально показано, что белки M. methylotrophus способны выполнять функцию своих аналогов из клеток E. coli не только при формировании транспозосомы, но и обеспечивать репликативный синтез и все последующие стадии репликативной транспозиции mini-Mu.
1.4. FLP-FRT-зависимое удаление интегрированного KmR-маркера из
хромосомы метилотрофов.
В нашей работе в качестве селективного маркера искусственного mini-Mu-транспозона был использован ген KmR, фланкированный рекомбиногенными участками FRT. На заключительном этапе эксперимента по интеграции фрагментов целевой ДНК практически важный интерес представляло удаление маркера устойчивости к антибиотику с сохранением в геноме остальных элементов mini-Mu-транспозона.
Для демонстрации такой возможности в клетках M. methylotrophus первоначально было осуществлено конструирование плазмиды pFLP31 (Рис. 4). Фрагмент ДНК, содержащий ген FLP-рекомбиназы дрожжей S. cerevisiae, а также ген термочувствительного репрессора lcIts857 и способный обеспечить в бактериальных клетках регулируемую экспрессию гена FLP-рекомбиназы за счет транскрипции с промотора PR бактериофага l, был переклонирован из плазмиды pCP20 (Datsenko K. and Wanner B., 2000) в состав вектора широкого круга микроорганизмов pAYCTER3 (ApR, IncQ).
Рис. 4. Структура плазмиды pFLP31, способной обеспечить термоиндуцибельный синтез FLP-рекомбиназы S. cerevisiae в клетках E. coli и M. methylotrophus.
С использованием полученной плазмиды удалось с высокой эффективностью, в 99%, удалить селективный маркер из хромосомы клонов-интегрантов M. methylotrophus AS1::FRT-KmR-FRT. Специфическое удаление KmR-маркера в результате FLP-FRT-зависимой сайт-специфической рекомбинации при сохранении остальной части mini-Mu-транспозона в составе бактериальной хромосомы M. methylotrophus было подтверждено методом PCR.
1.5. Последовательная Mu-зависимая транспозиция нескольких генов
в M. methylotrophus.
Возможность множественной модификации хромосомы с использованием Mu-зависимой транспозиции была продемонстрирована на примере последовательной интеграции в геном M. methylotrophus гетерологичных генов α-амилазы B. amyloliquefaciens и катехол-2,3-диоксигеназы P. putida.
Рис. 5. Качественное определение активности α-амилазы (зоны гидролиза крахмала) и С230 (желтое окрашивание) в клетках интегрантов M. methylotrophus AS1.
Первым в хромосому M. methylotrophus был итегрирован ген amyE B. amyloliquefaciens (Smirnova N. et al, 1988), экспрессия которого детектировалась по зонам гидролиза крахмалосодержащей среды вокруг соответствующих клонов (Рис. 5). Затем после FLP-зависимого удаления маркера KmR удалось с высокой эффективностью селективно интегрировать в Amy+-варианты M. methylotrophus AS1::amyE mini-Mu транспозон, содержащий xylE ген P. putida mt-2 (Inouye, S. et al, 1981). Катехол 2,3-диоксигеназа (С23О) катализирует расщепление катехола до полуальдегида мукановой кислоты, раствор которой имеет интенсивно желтый цвет. Поэтому экспрессия в бактериальных клетках гена xylE легко регистрируется (Zukowski, M. et al, 1983). Экспрессия обоих генов в двойном мутанте M. methylotrophus AS1::amyE+xylE+ была подтверждена экспериментально (Рис. 5).
1.6. Амплификация mini-Mu в хромосоме M. methylotrophus.
Поскольку в нашей работе мы показали, что интеграция mini-Mu в геном M. methylotrophus происходит преимущественно по механизму репликативной транспозиции, за счет этого механизма могла быть осуществлена амплификация интегрированных фрагментов ДНК в бактериальной хромосоме. В качестве селективного маркера для регистрации амплификации mini-Mu мы использовали гены устойчивости к стрептомицину. Для этого был сконструирован mini-Mu транспозон, содержащий гены strAB под транскрипционным контролем метилотрофного промотора P17 (Abalakina E. et al., 2008), и копия mini-Mu транспозона {[FRT-KmR-FRT]-SmR} была интегрирована в хромосому M. methylotrophus по маркеру устойчивости к канамицину. Было показано, что одна копия генов strAB обеспечивает устойчивость клеток M. methylotrophus к 500 мкг/мл стрептомицина, тогда как амлификация на плазмиде средней копийности – свыше 10 мг/мл. Следовательно, можно было ожидать, что при амплификации интегрированной в хромосому копии mini-Mu {[FRT-KmR-FRT]-SmR}, клетки также приобретут способность расти на повышенных концентрациях антибиотика. В соответствии с этим клоны, содержащие амплифицированный mini-Mu транспозон, отбирали на концентрациях Sm 2 мг/мл. Амплификацию проводили следующим образом. В клетки, содержащие интегрированный в хромосому mini-Mu транспозон {[FRT-KmR-FRT]-SmR}, вводили нестабильную хелперную плазмиду pTP310. Затем проводили термоиндукцию синтеза факторов транспозиции и отбирали клоны, устойчивые к высоким концентрациям Sm. Наличие амплификации mini-Mu транспозона в хромосоме подтверждали гибридизацией по Саузерну (Рис. 6).
Как видно из рисунка 6 отобранные клоны имели, как минимум, две копии mini-Mu в своем геноме, и, следовательно, принципиальная возможность внутрихромосомальной амплификации mini-Mu за счет репликативной транспозиции с образованием коинтегратов была показана. Однако частота возникновения устойчивых к высокой концентрации стрептомицина (2 мг/мл) клонов по отношению к общему количеству клеток, взятых для индукции транспозиции устойчивых к низкой концентрации Sm (500 мкг/мл), т. е. частота амплификации, была достаточно низкой 2х10-4. Это не только делало практически невозможным отбор вариантов с большим уровнем амплификации в неселективных условиях, но и сильно ограничивало само применение этой системы по сравнению с E. coli, где обнаружение множественных интеграций и амплификация первично интегрированной mini-Mu единицы являлись рутинной процедурой ( и др., 2007; и др., 2007).
А. Б.

Рис. 6. Результаты ДНК-гибридизации по Саузерну клонов M. methylotrophus AS1, содержащих в хромосоме копии mini-Mu транспозона {[FRT-KmR-FRT]-SmR}. Изолированная из клеток хромосомная ДНК была гидролизована нуклеазой EcoRV, полученные в результате фрагменты ДНК разделены с помощью электрофореза в агарозном геле (Б) и гибридизованы с меченым зондом (А): дорожка 1 – маркер, дорожка 2 – контроль – клон M. methylotrophus AS1::{[FRT-KmR-FRT]-SmR}, отобранный в результате первичной интеграции mini-Mu в хромосому (устойчивость к SmR – 500 мг/л), дорожки 3 - 7 – клоны M. methylotrophus AS1::{[FRT-KmR-FRT]-SmR}, отобранные после процедуры амплификации mini-Mu в хромосоме (устойчивость к SmR – 2 г/л), дорожка 8 – отрицательный контроль – M. methylotrophus AS1 (дикий тип).
1.7. Исследование влияния энхансерной последовательности бактериофага Mu (IAS) на амплификацию интегрированных фрагментов ДНК в бактериальном геноме.
Возможный путь модификации системы был выбран в соответствии с современными представлениями о механизмах транспозиции бактериофага Mu. Как известно в настоящее время, на ранней стадии реакции транспозиции сложный цикл взаимодействий между субъединицами MuА, связывающими правый конец (R), энхансер (Е), а затем и левый конец (L), активизирует образование временного синаптического комплекса LER. После образования нестабильного короткоживущего LER-комплекса транспозиция Mu проходит через серию стабильных высокоупорядоченных нуклеопротеиновых комплексов, называемых транспозосомами. Присутствие Mu энхансера является важным фактором правильной сборки транспозосомы (Yin et al., 2007).
В созданной ранее Mu-производной двухплазмидной системе энхансер был расположен лишь в составе хелперной плазмиды (энхансерная область фага Mu или IAS (internal activation sequence) перекрывается с О1 и О2 операторами для с-репрессора), и, следовательно, Е-элемент мог участвовать в процессе сборки Mu транспозосомы, только находясь в положении in trans относительно mini-Mu единицы.
Было решено исследовать процесс Mu-зависимой транспозиции в M. methylotrophus в случае, когда энхансер расположен между левым и правым att сайтами mini-Mu. Для этого были созданы новые интегративные векторы на основе плазмиды pАH162 с γ-репликоном R6K (Kolter R., 1981) (Рис. 7).

Рис. 7. Физико-генетическая карта интегративных плазмид: (А) p17DenhSm, (Б) p17enhSm.
Структура генетического элемента mini-Mu одного из вновь сконструированных векторов p17DenhSm была аналогична ранее используемым интегративным векторам (Рис. 7 А), а в состав mini-Mu транспозона второго p17enhSm был клонирован фрагмент ДНК размером 350 пар нуклеотидов, содержащий энхансерную последовательность бактериофага Mu (IAS) (Рис. 7 Б). В качестве внутренних селективных маркеров mini-Mu как и в предыдущих экспериментах были использованы: ген устойчивости к Km, по которому проводили отбор первичной интеграции, и гены strAB, позволяющие регистрировать амплификацию mini-Mu в хромосоме.
|
Из за большого объема этот материал размещен на нескольких страницах:
1 2 |



